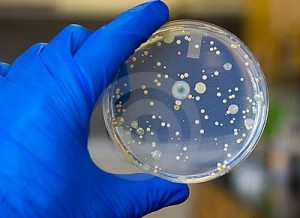
20160927152829742

دسته : (علمی و آموزشی) توسط tebbazar در ۰۷-۰۷-۱۳۹۵
بیماری های قلبی عروقی جزو بیماری های غیرواگیر و مزمن هستند که علاوه بر این بیماری، سرطان ها، دیابت و فشار خون نیز جزو این بیماری ها محسوب می شوند.بیماریهای قلبی عروقی در زمان حاضر جزو سه علت نخست مرگ و میر و ناتوانی انسان در سراسر دنیا به شمار می رود و در زمان حاضر در حال تبدیل شدن به اصلی ترین عامل مرگ و میر یا ناتوانی در بسیاری از کشورهاست.خطرات ناشی از بیماری های عفونی و مسری بر عکس بیماری های غیرواگیر به دلیل ماهیت واگیری آنها سریع و قابل مشاهده فوری است.

ادامه این مطلب را بخوانید »
دسته : (علمی و آموزشی) توسط tebbazar در ۰۷-۰۷-۱۳۹۵
دکتر مسعود قاسمی در این خصوص اظهار کرد: پیشگیری اولیه از بیماریهای قلبی – عروقی و همچنین موضوع رفتارهای اجتماعی و فرهنگی شامل تغذیه، حرکت، فعالیتهای عمومی و مشاوره برای کسانی که زمینه برخی بیماریها مانند دیابت را از کودکی دارند، باید اصل و مبنای توجه باشد.

ادامه این مطلب را بخوانید »
دسته : (علمی و آموزشی) توسط tebbazar در ۰۷-۰۷-۱۳۹۵
زیکاویروس که ناقل آن حشره است باعث شده تا سازمان کنترل و پیشگیری بیماری ایالات متحده هشداری را برای امریکای مرکزی، امریکای جنوبی و کاراییب صادر کند. این آژانس به زنان حامله هشدار داده که بهتر است سفر خود به ۱۴ کشور و ناحیه را به تعویق بیاندازند.
ادامه این مطلب را بخوانید »
دسته : (علمی و آموزشی) توسط tebbazar در ۰۷-۰۷-۱۳۹۵
یک روانشناس گفت: مصرف مواد غذایی با طعم های مختلف با شخصیت رفتاری و حالات روحی انسان رابطه دارد.در فصل پاییز این مواد غذایی را مصرف کنیدرضا اصغری روانشناس گفت: مصرف مواد غذایی با طعم های مختلف بر روح، روان و دستگاه گوارشی انسان تاثیر بسزایی دارد.

ادامه این مطلب را بخوانید »
دسته : (علمی و آموزشی) توسط tebbazar در ۰۶-۰۷-۱۳۹۵
محققان دانشگاه استنفورد با استفاده از نانو ذرات آهن موفق به تحریک سیستم ایمنی و درمان سرطان شدند.نانوذرات آهن ماکروفاژ های مربوط به تومور را در سیستم ایمنی تحریک کرده و سبب می شوند سیستم ایمنی با بیماری مبارزه کند.
ادامه این مطلب را بخوانید »
دسته : (علمی و آموزشی) توسط tebbazar در ۰۶-۰۷-۱۳۹۵
دکتر سعید کابلی، مخمر “ساکارو میسس سرویزیه” را میکروارگانیسم غیر بیماریزا دانست و گفت: این میکروارگانیسم به دلیل تحمل بالا نسبت به استرسهای متعدد محیطی و دستکاریهای ژنتیکی انسان، توانسته است در سالهای اخیر در تولید متابولیتهای با ارزش بالا مانند انواع داروهای ضد سرطان، در تولید سوختهای مهم زیستی و در تحقیقات پایه ژنتیکی نقش مهمی را ایفاء کند.
ادامه این مطلب را بخوانید »
دسته : (علمی و آموزشی) توسط tebbazar در ۰۶-۰۷-۱۳۹۵
علی ربانی فوق تخصص غدد و متابولیسم کودکان با اشاره به برگزاری همایش بین المللی بیماریهای کودکان ایران و چهاردهمین همایش پرستاری کودکان با گفت : این همایش به عنوان با قدمتترین همایش پزشکی کشور، سهم بسزایی در ارتقاء علمی طب کودکان در کشور دارد و هرساله برگزار می شود و امسال نیز بیست و هشتمین همایش بین المللی بیماریهای کودکان ایران به همت مرکز تحقیقات رشد و تکامل کودکان دانشگاه علوم پزشکی تهران و با همکاری مرکز طبی کودکان ، میزبان جمع کثیری از متخصصین بیماریهای کودکان و رشته هایی شامل جراحی کودکان، رادیولوژی کودکان، پزشکی اجتماعی و … است.

ادامه این مطلب را بخوانید »
دسته : (علمی و آموزشی) توسط tebbazar در ۰۶-۰۷-۱۳۹۵
سل به طور معمول به ریه ها حمله میکند، اما بر قسمتهای دیگر بدن نیز میتواند تأثیر گذار باشد.وقتی افرادی که عفونت سلی فعال دارند سرفه، عطسه و یا بزاق خود را از طریق هوا منتقل میکنند، سل از طریق هوا پخش میشود اما معمولاً از هر ده عفونت نهفته یک عفونت در نهایت پیشرفت کرده و به بیماری فعال تبدیل میشود.

ادامه این مطلب را بخوانید »
دسته : (علمی و آموزشی) توسط tebbazar در ۰۶-۰۷-۱۳۹۵
میگرن تنها یک سردرد ساده نیست. این در واقع یک بیماری بسیار پیچیده با طیف گستردهای از علائم ناتوان کننده است که بیشتر با سردردهای شدید مشخص میشود. سایر نشانهها ممکن است شامل حساسیت شدید دید به نور، صداها، بوهای خاص و نیز استفراغ و حالت تهوع باشد.با اینکه میگرن بسیار ناراحت کننده است اما روشهای ساده و موثری برای کنترل و مدیریت آن وجود دارد. در ادامه با ۱۰ مورد از این روشها آشنا خواهیم شد.
ادامه این مطلب را بخوانید »
دسته : (علمی و آموزشی) توسط tebbazar در ۰۵-۰۷-۱۳۹۵
رئیس فدراسیون جهانی انجمن جراحان مغز و اعصاب معتقد است: هر کشوری که ادعای مداوای بیماران مغز و اعصاب را با استفاده از سلول های بنیادین داشته باشد، به جامعه پزشکی خیانت کرده است.پروفسور سمیعی یکشنبه شب در نشست خبری در ساری گفت: هنوز تحقیقات استفاده از سلول های بنیادین در مداوای بیماری های مغز و اعصاب در دنیا به نتیجه مثبتی نرسیده است.

ادامه این مطلب را بخوانید »